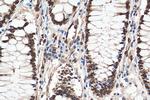
KU70 Antibody in Immunohistochemistry (Paraffin) (IHC (P))

Search
Proteintech
KU70 Polyclonal Antibody
{{$productOrderCtrl.translations['antibody.pdp.commerceCard.promotion.promotions']}}
{{$productOrderCtrl.translations['antibody.pdp.commerceCard.promotion.viewpromo']}}
{{$productOrderCtrl.translations['antibody.pdp.commerceCard.promotion.promocode']}}: {{promo.promoCode}} {{promo.promoTitle}} {{promo.promoDescription}}. {{$productOrderCtrl.translations['antibody.pdp.commerceCard.promotion.learnmore']}}
产品信息
10723-1-AP
种属反应
已发表种属
宿主/亚型
分类
类型
抗原
偶联物
形式
浓度
规格
纯化类型
保存液
内含物
保存条件
运输条件
产品详细信息
Immunogen sequence: TGGLLLPSD TKRSQIYGSR QIILEKEETE ELKRFDDPGL MLMGFKPLVL LKKHHYLRPS LFVYPEESLV IGSSTLFSAL LIKCLEKEVA ALCRYTPRRN IPPYFVALVP QEEELDDQKI QVTPPGFQLV FLPFADDKRK MPFTEKIMAT PEQVGKMKAI VEKLRFTYRS DSFENPVLQQ HFRNLEALAL DLMEPEQAVD LTLPKVEAMN KRLGSLVDEF KELVYPPDYN PEGKVTKRKH DNEGSGSKRP KVEYSEEELK THISKGTLGK FTVPMLKEAC RAYGLKSGLK KQELLEALTK HFQD (307-609 aa encoded by B C008343)
靶标信息
XRCC6 is a nuclear complex consisting of two subunits with molecular masses of approximately 70 and 80 kDa. The complex functions as a single-stranded DNA-dependent ATP-dependent helicase. The complex may be involved in the repair of nonhomologous DNA ends such as that required for double-strand break repair, transposition, and V(D)J recombination. High levels of autoantibodies to p70 and p80 have been found in some patients with systemic lupus erythematosus.
仅用于科研。不用于诊断过程。未经明确授权不得转售。
生物信息学
蛋白别名: 5'-deoxyribose-5-phosphate lyase Ku70; 5'-dRP lyase Ku70; 5'-dRP/AP lyase Ku70; 70 kDa subunit of Ku antigen; ATP-dependent DNA helicase 2 subunit 1; ATP-dependent DNA helicase II 70 kDa subunit; ATP-dependent DNA helicase II, 70 kDa subunit; CT; CTA-216E10.7; CTC box binding factor 75 kDa subunit; CTC box-binding factor 75 kDa subunit; CTC75; CTCBF; DNA repair protein Ku70; DNA repair protein XRCC6; G22P1; Ku autoantigen p70 subunit; Ku autoantigen protein p70 homolog; Ku autoantigen, 70kDa; Ku p70; Ku protein subunit; Ku70; Ku70 DNA-binding component of DNA-dependent proteinkinase complex (thyroid autoantigen 70 kDa); Lupus Ku autoantigen protein p70; OTTHUMP00000028581; p70 autoantigen; thyroid autoantigen; thyroid autoantigen 70 kDa; thyroid autoantigen 70kD (Ku antigen); thyroid autoantigen 70kDa (Ku antigen); Thyroid-lupus autoantigen; thyroid-lupus autoantigen p70; TLAA; unnamed protein product; X-ray repair complementing defective repair in Chinese hamster cells 6; X-ray repair cross-complementing protein 6
基因别名: 70kDa; CTC75; CTCBF; G22P1; KU70; Kup70; ML8; TLAA; XRCC6
UniProt ID: (Human) P12956, (Mouse) P23475
Entrez Gene ID: (Human) 2547, (Rat) 25019, (Mouse) 14375